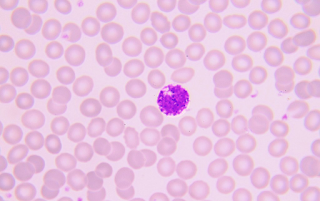

Hola Carlos, te mando los primeros ejercicios, ¿me podrías pasar los siguientes para ir avanzando?. Gracias.
martes, 26 de noviembre de 2019
miércoles, 6 de noviembre de 2019
martes, 5 de noviembre de 2019
lunes, 4 de noviembre de 2019
Leucocitos neutrófilos segmentado y cayado
domingo, 3 de noviembre de 2019
miércoles, 30 de octubre de 2019
Neutrofilo Cayado
Carr, J. & Rodak, B. (2010). Atlas de Hematología Clínica. (3ra. Ed.). Buenos Aires: Medica Panamericana.
Carlos Varas García
Basófilo
Página web: MedlinePlus, biblioteca nacional de medicina de EEUU
Imagen de archivo: obtenida de la enciclopedia ilustrada de la salud de A.D.A.M.
martes, 29 de octubre de 2019
miércoles, 23 de octubre de 2019
miércoles, 16 de octubre de 2019
Mielocito neutrofilo
Atlas de hematologia. George A. McDonald, James Paul, Bruce Crick shank. Editorial médica panamericana.
Carlos Varas García
Megacariocito
Fuente: Articulo de revisión "El megacariocito: una célula muy original"
Beatriz Gordo Herrero
martes, 15 de octubre de 2019
Suscribirse a:
Entradas (Atom)